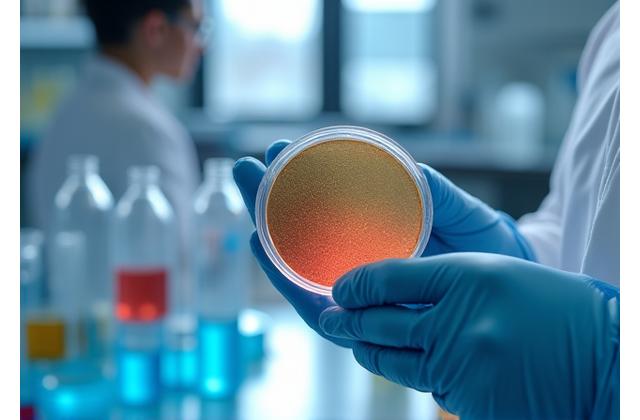

Vores Historie og Mission

Sølvfarvet Flugt blev grundlagt med en vision om at forene dansk designtradition med industriel præcision. Inspireret af Skandinaviens rene linjer og funktionalitet begyndte vores rejse med et fokus på at skabe pigmenter af uovertruffen kvalitet og æstetik.
Vi startede med et lille team af passionerede kemikere og ingeniører, der delte en fælles forpligtelse til innovation. Gennem årene har vi udviklet avancerede metoder til fremstilling af specialpigmenter, der ikke kun opfylder, men overgår industristandarderne.
At være den førende innovator
Vores mission er at være den førende innovator inden for specialpigmenter ved at kombinere bæredygtig produktion med kompromisløs kvalitet. Vi stræber efter at være den foretrukne partner for virksomheder, der søger enestående farveløsninger.
Vores Værdier:
- Kvalitet: Uovertruffen standard i hvert pigment vi producerer.
- Innovation: Konstant udvikling af nye teknologier og farveløsninger.
- Samarbejde: Tæt partnerskab med vores kunder for at realisere deres visioner.
- Bæredygtighed: Ansvarlig produktion og et grønt fodaftryk.
Forpligtet til Kvalitet

Grundig Kvalitetskontrol
Hvert parti pigmenter gennemgår en omfattende række af tests for at sikre ensartethed, farvestabilitet og ydeevne. Vores processer overholder de højeste internationale standarder.

Certificerede Standarder
Sølvfarvet Flugt er stolt certificeret efter ISO 9001 standarden, hvilket garanterer systematisk og stringent kvalitetsledelse i alle led af vores produktion og drift.

Etisk Råmateriale Indkøb
Vi udvælger omhyggeligt vores råmaterialer fra betroede leverandører, der deler vores engagement i bæredygtighed og etisk forretningspraksis, for at sikre både kvalitet og ansvarlighed.